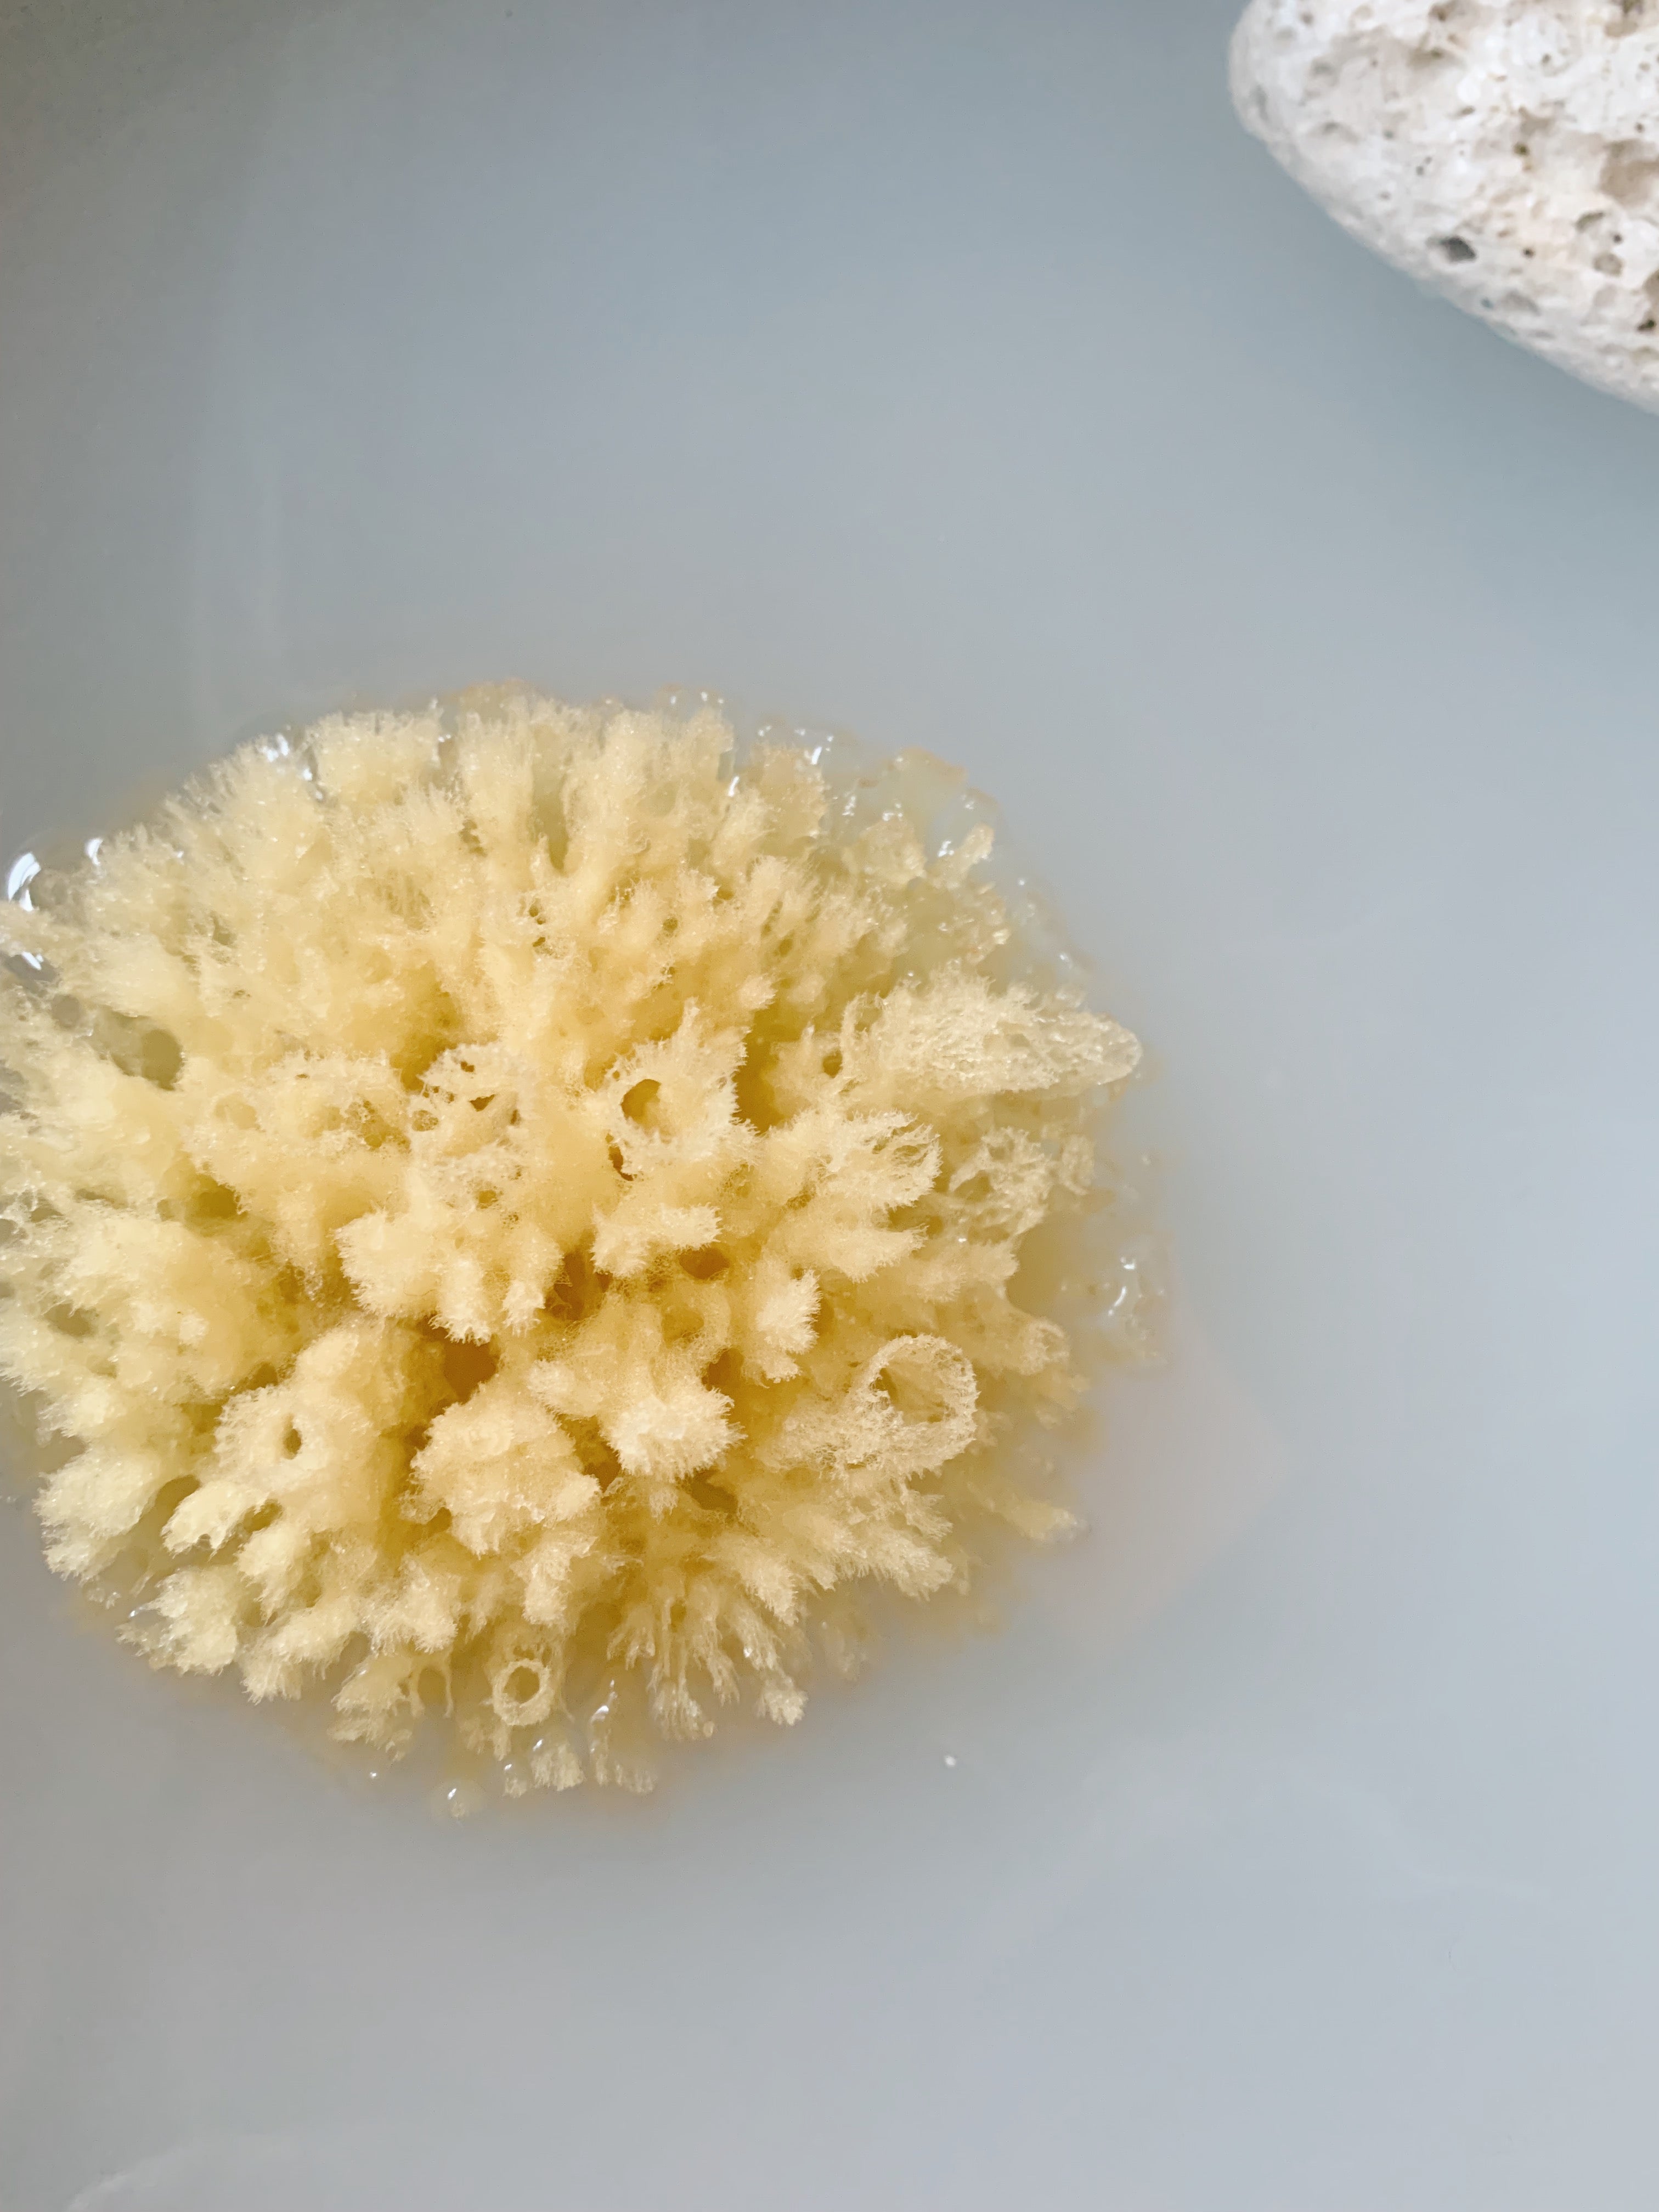

Naturlig Badesvamp
Naturlig Middelhavssvamp til Badning
Denne 100% naturlige badesvamp fra Middelhavet er blød mod huden og velegnet til brug af både voksne, børn og babyer.
Svampen vokser naturligt i Middelhavet på dybder fra 10 til 80 meter. Den håndplukkes af fiskere, og dens rod lades intakt for at muliggøre fortsat vækst.
Allergivenlig og slidstærk, har denne natursvamp en lang levetid, når den plejes korrekt og tørres mellem brug. Størrelsen og formen kan variere på grund af sin naturlige oprindelse.
Vælg muligheder

Naturlig Badesvamp
Salgspris100,00 DKK



